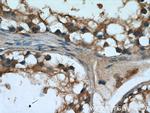
UPF3A Antibody in Immunohistochemistry (Paraffin) (IHC (P))
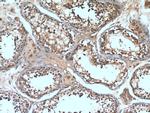
UPF3A Antibody in Immunohistochemistry (Paraffin) (IHC (P))

Search
Proteintech
UPF3A Polyclonal Antibody
{{$productOrderCtrl.translations['antibody.pdp.commerceCard.promotion.promotions']}}
{{$productOrderCtrl.translations['antibody.pdp.commerceCard.promotion.viewpromo']}}
{{$productOrderCtrl.translations['antibody.pdp.commerceCard.promotion.promocode']}}: {{promo.promoCode}} {{promo.promoTitle}} {{promo.promoDescription}}. {{$productOrderCtrl.translations['antibody.pdp.commerceCard.promotion.learnmore']}}
产品信息
17114-1-AP
种属反应
已发表种属
宿主/亚型
分类
类型
抗原
偶联物
形式
浓度
规格
纯化类型
保存液
内含物
保存条件
运输条件
产品详细信息
Immunogen sequence: AHDYFEFFA ADLSLYPHLY SRAYINFRNP DDILLFRDRF DGYIFLDSKD PEYKKFLETY CVEEEKTSAN PETLLGEMEA KTRELIARRT TPLLEYIKNR KLEKQRIREE KREERRRREL EKKRLREEEK RRRREEERCK KKETDKQKKI AEKEVRIKLL KKPEKGEEPT TEKPKERGEE IDTGGGKQES CAPGAVVKAR PMEGSLEEPQ ETSHSGSDKE HRDVERSQEQ ESEAQRYHVD DGRRHRAHHE PERLSRRSED EQRWGKGPGQ DRGKKGSQDS GAPGEAMERL GRAQRCDDSP APRKERLANK DRPALQLYDP GARFRARECG GNRRICKAEG SGTGPEKREE AE (93-443 aa encoded by BC023569)
靶标信息
UPF3A is part of a multiprotein post-splicing mRNP complex involved in both mRNA nuclear export and mRNA surveillance. UPF3A is involved in nonsense-mediated decay (NMD) of mRNAs containing premature stop codons.
仅用于科研。不用于诊断过程。未经明确授权不得转售。
生物信息学
蛋白别名: hUpf3; involved in NMD pathway; Nonsense mRNA reducing factor 3A; Regulator of nonsense transcripts 3A; unnamed protein product; Up-frameshift suppressor 3 homolog A; UPF3 regulator of nonsense transcripts homolog A
基因别名: HUPF3A; RENT3A; UPF3; UPF3A
UniProt ID: (Human) Q9H1J1
Entrez Gene ID: (Human) 65110